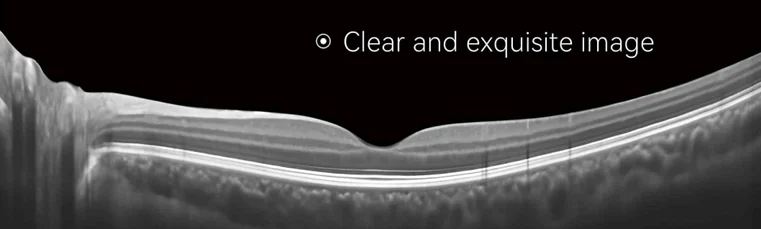

OCT20 Ophthalmic Optical Oct Machine Analysis Fundus Diseases Optical Coherence Tomography
- Category: >>>
- Supplier: Eo Medical Equipment Co. Ltd.Eo Ltd.
Share on (1601239418268):
Product Overview
Description
Product Description

High Speed OCT Imaging
Clear and exquisite image
Macula Area and Optic disk Area
“Hold A Panoramic View”
Scanning range up to 13mm

Macula Analysis FunctionN

1. Binocular Contrast
2. Follow-up Comparison
3. Analysis Report

GCC Thickness Analysis

RNFL Thickness Analysis

1. Binocular Contrast
2. Follow-up Comparison
3. Analysis Report

9mm High-Definition Linear Scanning of Cornea of Anterior Segment Single-line
HD scan, multiple images combined to produce better image, clear cornea structure.Auto measurement and manual measurement for each cornea layer thickness.

Clearly showing the cornea and iris.
Accurate scanning of chamber angle, with high-definition display of the structure.

HD Fundus imaging
Detachment of neurosensory retina in macula area,and no-signal dark cavity and globular hyper reflex signal can be seen under it.
Fovea centralis disappeared, edema and thickening of macular retinal, cystic dark cavity and detachment of neurosensory retina can beseen under it.
The fovea centralis disappears, the inner layer is locally raised, and the cystic dark cavity with irregular boundary was visible.The RPE band was intact.
Choroid gets thinning.
"Curve" changes of retina, disorder of RPE structure, signal enhancement, partial disappearance of signal band and thinning of choroid.
A band of hyper reflex signal attached to the anterior retina and retinal edema thickening.
A band of hyper reflex signal can be seen floating in the front of the retina,the whole neurosensory retina is broken,and there is fluid accumulation in the outer plexiform layer of retina at the margin of the tear, forming cystoid edema.
Retinal edema, cystic dark cavity and non-reflected signal dark area under it, detachment of neurosensory retina.
Technical Parameter
Optical Coherence Tomography lmage | ||
Mode | Frequency Domain OCT | |
Light Source | Super Light Diode (SLD),843nm | |
Scanning Speed | 60kHz | |
Axial Resolution | ≤5um (In the organization) | |
Lateral Resolution | ≤13um (In the organization) | |
Scanning Depth | 3.5mm (In the organization) | |
Refractive Compensation Range | -20D~+20D | |
Scan Mode | Single-line scan, multi-line scan, regional scan, radiological scan, anterior segment scan | |
Fundus Image | ||
Mode | Linear Scanning Ophthalmoscope (LSO) | |
Field of View | 45° | |
Other Parameters | ||
Weight | 100kg | |
Dimension | 110cm (L) x 63cm (W) × 130cm (H) | |
Power Supply | 220V~, 50Hz,450VA | |
Details Images
Packing & Delivery
Safe foam carton package to protect the Product well. Delivery: By DHL, UPS, TNT, FeDex, Air.

Company Profile



EO-Med Equipment Co., Ltd. was established in 2001. It is located in Guangdong province. We are a professional manufacturer, committed to R&D, producing & marketing advanced medical equipment, with the advanced facilities and scientific management system. We have one of the biggest factory in medical field, covering 50,000 square meters, over 1100 staff. We are specialized in producing a series of medical products, our main products include ultrasound machines, X-ray machine, anti-radiation wears, dental chairs & units, lab equipment, ECG, patient monitor, ICU equipment, for human & veterinary. Our factory has passed ISO 9001:2000. We have exported products to more than 60 countries and built long term partnerships with clients.
Your satisfaction is our duty! It will be our great honor to serve you. We do hope we can offer you more help in medical field and build the long term business relationship with you.
Your satisfaction is our duty! It will be our great honor to serve you. We do hope we can offer you more help in medical field and build the long term business relationship with you.
We Recommend
New Arrivals
New products from manufacturers at wholesale prices



















